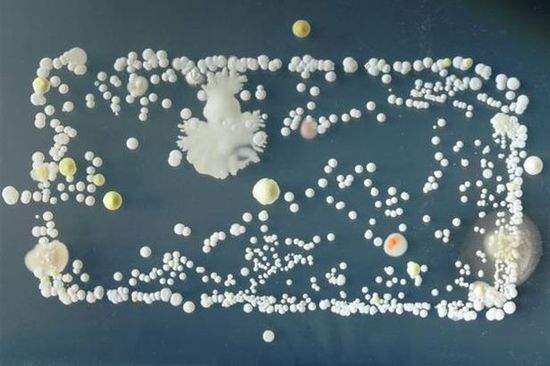
Bakterien auf Smartphones

«Dravens Tales from the Crypt» bezaubert seit über 15 Jahren mit einer geschmacklosen Mischung aus Humor, seriösem Journalismus – aus aktuellem Anlass und unausgewogener Berichterstattung der Presse Politik – und Zombies, garniert mit jeder Menge Kunst, Entertainment und Punkrock. Draven hat aus seinem Hobby eine beliebte Marke gemacht, welche sich nicht einordnen lässt.
«Dravens Tales from the Crypt» bezaubert seit über 15 Jahren mit einer geschmacklosen Mischung aus Humor, seriösem Journalismus – aus aktuellem Anlass und unausgewogener Berichterstattung der Presse Politik – und Zombies, garniert mit jeder Menge Kunst, Entertainment und Punkrock. Draven hat aus seinem Hobby eine beliebte Marke gemacht, welche sich nicht einordnen lässt.
Mein Blog war niemals darauf ausgelegt Nachrichten zu verbreiten, geschweige denn politisch zu werden, doch mit dem aktuellen Zeitgeschehen kann ich einfach nicht anders, als Informationen, welche sonst auf allen anderen Kanälen zensiert werden, hier festzuhalten. Mir ist dabei bewusst, dass die Seite mit dem Design auf viele diesbezüglich nicht «seriös» wirkt, ich werde dies aber nicht ändern, um den «Mainstream» zu gefallen. Wer offen ist, für nicht staatskonforme Informationen, sieht den Inhalt und nicht die Verpackung. Ich habe die letzten 2 Jahre genügend versucht, Menschen mit Informationen zu versorgen, dabei jedoch schnell bemerkt, dass es niemals darauf ankommt, wie diese «verpackt» sind, sondern was das Gegenüber für eine Einstellung dazu pflegt. Ich will niemandem Honig ums Maul schmieren, um auf irgendwelche Weise Erwartungen zu erfüllen, daher werde ich dieses Design beibehalten, denn irgendwann werde ich diese politischen Statements hoffentlich auch wieder sein lassen können, denn es ist nicht mein Ziel, ewig so weiterzumachen  Ich überlasse es jedem selbst, wie er damit umgeht. Gerne dürfen die Inhalte aber auch einfach kopiert und weiterverbreitet werden, mein Blog stand schon immer unter der WTFPL-Lizenz.
Ich überlasse es jedem selbst, wie er damit umgeht. Gerne dürfen die Inhalte aber auch einfach kopiert und weiterverbreitet werden, mein Blog stand schon immer unter der WTFPL-Lizenz.
Es fällt mir schwer zu beschreiben, was ich hier eigentlich tue, DravensTales wurde im Laufe der Jahre Kulturblog, Musikblog, Schockblog, Techblog, Horrorblog, Funblog, ein Blog über Netzfundstücke, über Internet-Skurrilitäten, Trashblog, Kunstblog, Durchlauferhitzer, Zeitgeist-Blog, Schrottblog und Wundertütenblog genannt. Was alles etwas stimmt… – und doch nicht. Der Schwerpunkt des Blogs ist zeitgenössische Kunst, im weitesten Sinne des Wortes.
Um den Betrieb der Seite zu gewährleisten könnt ihr gerne eine Spende per Kreditkarte, Paypal, Google Pay, Apple Pay oder Lastschriftverfahren/Bankkonto zukommen lassen. Vielen Dank an alle Leser und Unterstützer dieses Blogs!

«Dravens Tales from the Crypt» bezaubert seit über 15 Jahren mit einer geschmacklosen Mischung aus Humor, seriösem Journalismus – aus aktuellem Anlass und unausgewogener Berichterstattung der Presse Politik – und Zombies, garniert mit jeder Menge Kunst, Entertainment und Punkrock. Draven hat aus seinem Hobby eine beliebte Marke gemacht, welche sich nicht einordnen lässt.
«Dravens Tales from the Crypt» bezaubert seit über 15 Jahren mit einer geschmacklosen Mischung aus Humor, seriösem Journalismus – aus aktuellem Anlass und unausgewogener Berichterstattung der Presse Politik – und Zombies, garniert mit jeder Menge Kunst, Entertainment und Punkrock. Draven hat aus seinem Hobby eine beliebte Marke gemacht, welche sich nicht einordnen lässt.







